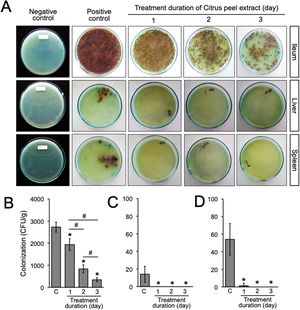
Bacterial load after the oral administration of Citrus peel extract. The colonies were evaluated every 24h for three days. (A) Growth of S. typhimurium colonies on BSA medium; (B–D) Bacterial load in the ileum, liver, and spleen of S. typhimurium infected-model, respectively. Data are expressed as a mean±standard deviation (SD). (*) and (#) indicates a significant difference compared to control and between two groups indicated in the graphs (p<0.05), respectively.

Citrus hystrix is widely used by Indonesians as a traditional medicine for gastrointestinal diseases, including Salmonella spp. infection. We investigated the antibacterial activity of the ethanolic peel extract of C. hystrix against Salmonella typhimurium.
MethodsThe antibacterial activity was evaluated both in vitro and in vivo. The minimum inhibitory concentration (MIC) of the extract was determined at a concentration of 0.625% by agar dilution assay. Later, the in vivo antibacterial activity was examined by the administration of 16mg of the extract daily for three consecutive days in a mouse model infected with S. typhimurium.
ResultsThe bacterial loads of S. typhimurium in the ileum, liver, and spleen decreased after 24h of administration of the extract (p=0.00008, p=0.00084, and p=0.00003, respectively).
ConclusionThe ethanolic peel extract of C. hystrix shows antibacterial activity against S. typhimurium, indicating the potential of C. hystrix as an effective treatment for Salmonella spp. infection.
El Citrus hystrix es muy utilizado por los indonesios como medicina tradicional para las enfermedades gastrointestinales, incluida la infección por Salmonella spp. Investigamos la actividad antibacteriana del extracto etanólico de piel de C. hystrix frente a Salmonella typhimurium.
MétodosLa actividad antibacteriana se evaluó tanto in vitro como in vivo. La concentración mínima inhibitoria (CMI) del extracto se determinó a una concentración del 0,625% mediante un ensayo de dilución en agar. Posteriormente, se evaluó la actividad antibacteriana in vivo mediante la administración de 16mg de extracto de forma diaria durante 3 días consecutivos en un modelo murino infectado con S. typhimurium.
ResultadosLa carga bacteriana de S. typhimurium en el íleo, el hígado y el bazo se redujo 24h después de la administración del extracto (p=0,00008, p=0,00084 y p=0,00003, respectivamente).
ConclusiónEl extracto etanólico de piel de C. hystrix muestra actividad antibacteriana frente a S. typhimurium, lo que indica el potencial de C. hystrix como tratamiento eficaz para la infección por Salmonella spp.
Salmonella spp. are gram negative bacteria that are associated with food and water-borne gastroenteritis and typhoid fever in humans.1 Systemic infections caused by Salmonella enterica serotype Typhi (S. typhi) remain a public health concern in developing countries, including Indonesia due to a high incidence rate. A study at the slums of Jakarta province, estimated the incidence rate of typhoid at 148.7, 180.3, and 51.2 per 100,000 person-years in the age groups of 2–4, 5–15, and over 16 years of age, respectively.2 Furthermore, a community-based case-control study conducted at the Jatinegara district, Jakarta, found that 9% and 3% of 1019 patients with fever, presented S. typhi and S. paratyphi infections, respectively.3 A study reported that patients receiving appropriate therapy may reduce the case-fatality rate of typhoid fever to 1–4%.4 Nonetheless, the proportion of multi-drug resistant (MDR) S. typhi tends to increase in several areas in Indonesia.2,5 Thus, MDR typhoid fever may become a serious problem and requires further appropriate treatment in the future.
Citrus hytrix (Indonesian name Jeruk purut) is a member of the genus Citrus, family Rutaceae, and has been used as a key ingredient in Southeast Asian cuisines. In Indonesia, the use of Citrus is not limited to culinary purpose but also as a remedy for respiratory and gastrointestinal disorders, including Salmonella spp. infections, although the mechanism of action remains unclear. Interestingly, mice infected with S. typhimurium mimic typhoid like-disease.1 Therefore, this study aims to investigate the antibacterial activity of the ethanolic peel extract of C. hystrixin vitro and in vivo in a mice model of Salmonella enterica serotype Typhimurium (S. typhimurium) infection.
MethodsPlant material and extract preparationThe fruit peels of C. hystrix were collected from Malang, East Java, Indonesia. The species of Citrus was identified and confirmed by a plant taxonomist of the herbarium unit, UPT Materia Medica, Batu, East Java, Indonesia. Duplicate voucher specimens have been deposited in the herbarium unit, UPT Materia Medica, Batu, East Java, Indonesia. The extract was prepared as previously described.6 Briefly, the fruit peels were shade dried and ground into a fine powder. Thirty grams of fruit peel powder were then macerated in 100ml absolute ethanol for 48h by the Soxhlet extraction apparatus. The extract was evaporated to dry at 40°C using a rotary evaporator and stored at 4°C for further use.
Bacterial isolateS. typhimurium was provided by the Department of Clinical Microbiology, Faculty of Medicine, Brawijaya University and identification was confirmed by the Microbact™ Gram-negative system.
Determination of the minimum inhibitory concentrationThe agar dilution method was used to determine the MIC of the ethanolic peel extract of C. hystrix, as described by Bailey and Scott's Diagnostic Microbiology.7 Twofold serial dilutions of the extract (0.3125%, 0.625%, and 1.25%) were prepared in Mueller Hinton agar for the agar dilution assay. Ten microliters of bacterial inoculum were delivered onto the agar with the final inoculum of 106CFU/ml. Bacterial plates were incubated at 37°C and evaluated after 24h.
Animal infection and tissue samplesFemale Balb/c mice between 8 and 12 weeks of age were obtained from the Faculty of Medicine, Gadjah Mada University and used in this study. This experiment was divided into two sequential approaches. First, to elucidate the initial stage of transient primary bacteremia in the animal model, thirty-five mice were infected orally with 0.5ml of 108CFU/ml S. typhimurium. Tissue collection procedures were initiated after the mice have been euthanized with isoflurane overdose (mice were placed into a chamber filled with a 5% vapor of the anesthetic isoflurane until respiration ceased, approximately within 2min). Five mice per day were sacrificed, bacterial counts in the ileum, liver, and spleen were evaluated from day 1 to day 7 post-infection (Fig. 1A). No colonization was observed in the uninfected control (data not shown). One hundred grams of the organs were homogenized and diluted in 2ml of nutrient broth. Ten-microliters of each samples were then cultured onto solid bismuth sulfite agar (BSA) and incubated at 37°C overnight. The number of S. typhimurium colonies were enumerated in CFU/g. For each sample, the quantification was done in triplicate. Second, to evaluate the antibacterial activity of the ethanolic peel extract of C. hystrixin vivo, twenty-five mice were randomly divided into five groups (5 mice each group), which were negative control, positive control, and infected mice treated with the extract orally for one day, two days and three days. The duration of S. typhimurium infection was seven days. Five mice of each infected group were sacrificed within 24h after the last administration of the extract, whereas negative and positive controls were sacrificed at the same time as corresponds to the treatment groups (Fig. 1B). The in vivo dose of the extract was quantified by converting % MIC into mg/ml, and then the result was multiplied by a total blood volume of mice.8 The extract was diluted in distilled water and given orally for 0.5ml per mouse. The ileum, liver, and spleen were collected and cultured on BSA. Bacterial load was expressed as CFU/g. No colonization was observed in the negative control. The study was approved by the medical ethics committee of the Faculty of Medicine, Brawijaya University, Malang, Indonesia (Reference No. 25-KE).
Statistical analysisBacterial load was analyzed by one-way ANOVA, followed by Tukey's post hoc test using StatPlus. Significant differences were accepted when p<0.05.
Results and discussionWe evaluated the growth of S. typhimurium isolated from the ileum, liver, and spleen on the BSA medium at day-1 to 7 post-infection (Supplementary Table 1). The number of bacterial colonies isolated from ileum was significantly increased at day-6 post-infection (p=0.02) (Fig. 2A) and nearly a 3-folde increased at day-7 post-infection (p=0.0001) (Fig. 2B). In this study, the colonization of S. typhimurium in the liver and spleen were found at day-7 post-infection, two more days than previously reported.9 These differences may be due to individual variation of the immune response among mice model and the inoculum concentration of S. typhimurium. Together, these results suggest that bacteria might be released into the bloodstream between day-5 and 7 post-infection.
(A) Growth of S. typhimurium colonies on BSA medium. (B) Bacterial load in the ileum, liver, and spleen of S. typhimurium infected-model. Data are expressed as a mean±standard deviation (SD). (*) and (#) indicate a significant difference compared to day-1 post-infection and between two groups indicated in the graphs (p<0.05), respectively.
A previous report in our laboratory demonstrated that the MIC and minimum bactericidal concentration (MBC) of the ethanolic peel extract of C. hystrix against S. typhi were 0.625% and 1.25%, respectively.10 In the same way, our study revealed that the MIC value of the ethanolic peel extract of C. hystrix against S. typhimurium was 0.625% (data not shown), which then was converted into 16mg (given orally in 0.5ml/day for 3 days) for in vivo experiments. The administration of the extract was given at day-7 post-infection. Our results showed that the administration of the ethanolic peel extract of C. hystrix inhibited significantly the colonization of S. typhimurium in the ileum, liver, and spleen after 24h (p=0.00008, p=0.00084, and p=0.00003, respectively) (Supplementary Table 2, Fig. 3A–D). Thus, our study suggests that daily oral administration of the ethanolic peel extract of C. hystrix at 16mg is effectively inhibiting the colonization of S. typhimuriumin vivo and might be a potential alternative treatment for Salmonella infections.
Bacterial load after the oral administration of Citrus peel extract. The colonies were evaluated every 24h for three days. (A) Growth of S. typhimurium colonies on BSA medium; (B–D) Bacterial load in the ileum, liver, and spleen of S. typhimurium infected-model, respectively. Data are expressed as a mean±standard deviation (SD). (*) and (#) indicates a significant difference compared to control and between two groups indicated in the graphs (p<0.05), respectively.
Several major constituents have been identified in C. hystrix peel extract.11,12 Interestingly, Srifuengfung et al. demonstrated that two active compounds, α-terpineol and terpinene-4-ol, were more concentrated than the other constituents.12 Moreover, a previous report has shown that α-terpineol displays the most potent antibacterial activity in comparison with the other constituents.13 Both Gram-positive and Gram-negative bacteria exposed to α-terpineol exhibited morphostructural alterations, mainly causing pores on the outer membrane of S. typhimurium.14 Furthermore, α-terpineol is also able to induce lipid leakage of Gram-negative bacteria.15 Therefore, it is possible to speculate that the active compounds of C. hystrix peels extract might disrupt the membrane integrity of bacteria, which then influence its metabolism. However, further experiments are required to examine the molecular mechanisms of the ethanolic peel extract of C. hystrix against bacterial infections, particularly against these caused by Salmonella spp.
In conclusion, the ethanolic peel extract of C. hystrix exhibits antibacterial activity against S. typhimurium both in vitro and in vivo. These findings imply that peel extract of C. hystrix could be an alternative treatment for Salmonella infections. Further studies are required to define appropriate C. hystrix dosing regimens for Salmonella infections and to assess novel treatment strategies, including combination therapies.
Funding statementNone to declare.
Conflict of interestNone to declare.
The authors would like to thank Fitri Arkham Fauziah and Siti Wardah for their thoughtful comments toward improving our manuscript.